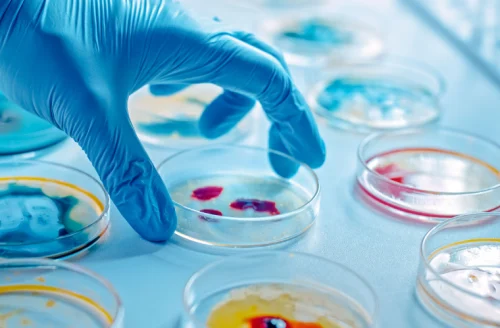

BIOSIMILARES
Numerosas publicaciones demuestran que el principal valor agregado atribuible a los medicamentos biosimilares es la posibilidad de que un mayor número de pacientes acceda a tratamientos biológicos. Es decir que, sea por reducción de costos respecto al producto original o por competitividad, los principales beneficiarios de la incorporación de los medicamentos biosimilares a los sistemas de salud son los pacientes.
La equivalencia entre el original y el biosimilar debe establecerse mediante un exhaustivo “ejercicio de comparabilidad” cuyo objetivo es demostrar que las leves diferencias inherentes al origen biológico y al proceso productivo de ambos compuestos no inciden en el perfil beneficio/riesgo. Esto permite sustentar que el principio activo de ambos medicamentos es, en esencia, el mismo.